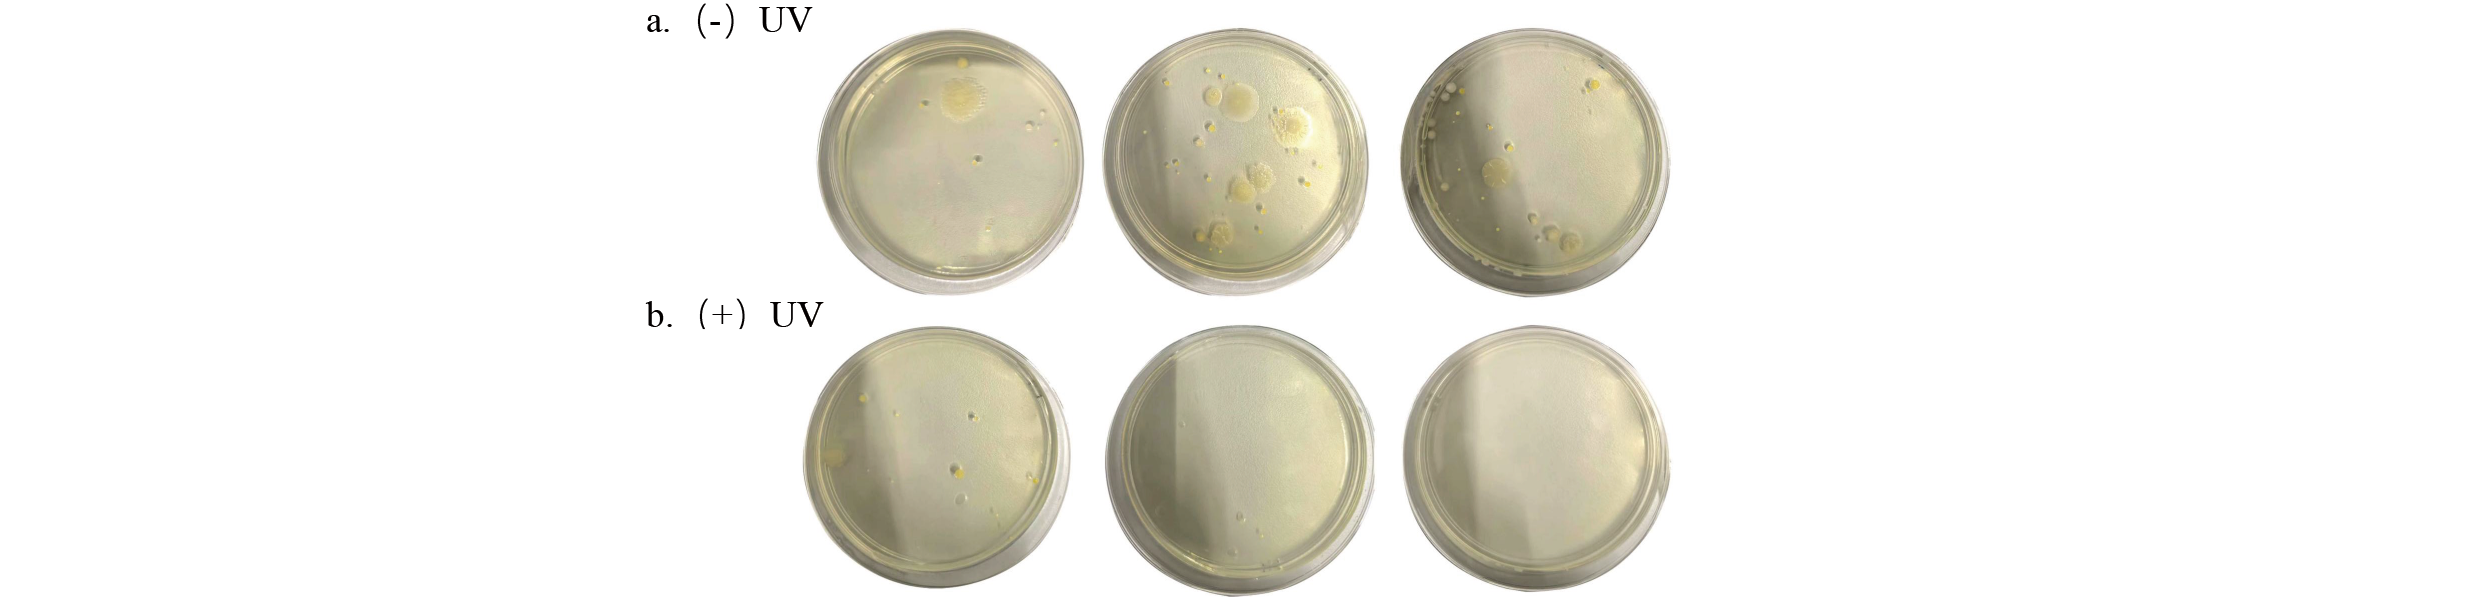
تطبيق التقنية في التقنية في AUV-C-CHED-AR-AIR-STERILIZER-REMOVAL (2) -3

تصفح الكمية:100 الكاتب:محرر الموقع نشر الوقت: 2025-07-24 المنشأ:محرر الموقع
Eason Liao*، Xiaoxiao Wang ، Guangjin Wang ، محمد شافا
Massphoton Limited Hong Kong ، HK1100 ، الصين
eason@massphoton.com ، 6195-6610
خلاصة
اكتسبت معقمات الجوية تبنيًا واسع النطاق في السوق ، لكن وظيفتها تظل مقصورة على أغراض فريدة مثل التطهير أو إزالة الرائحة. الحمض النووي و RNA تكرار. تم تركيبه على سقف غرف الاجتماعات ، وغرف القمامة ، والممرات في مركز تجاري يعمل عادة في هونغ كونغ ، وحقق معقم الهواء Q6060-D UV-C في Massphoton بمعدل تعقيم قدره 70.8 ٪ في غرفة القمامة و 61.62 ٪ في غرفة مقابلة. على الرغم من أنه أثناء اختبار إزالة الرائحة ، زادت أنشطة الطلاء الجداري في متجر مستأجر بشكل كبير من مستويات TVOC ، إلا أن استخدام معقم الهواء Massphoton يقلل من مستوى TVOC الأولي من 10.00 ملغ/متر مكعب إلى 3.53 ملغ/متر مكعب في غضون ساعتين. في اختبار محاكاة أجريت في غرفة 112 متر مكعب ، بعد أن تم حرق أربعة سجائر تمامًا ، تم تنشيط معقم الهواء UV-C من Massphoton Q6060-D على الفور. بعد 4 ساعات ، تم تخفيض تركيز PM2.5 بفعالية بنسبة 61.1 ٪ ، وتم تخفيض تركيز TVOC بنسبة 98.2 ٪. باستخدام محلول الأمونيا بنسبة 10 ٪ كاختبار غاز الأمونيا المتطاير ، بلغ معدل إزالة الأمونيا 99.9 ٪ في غضون 90 دقيقة. استنادًا إلى جميع النتائج التجريبية ، يمكن أن نستنتج أن معقم الهواء Q6060-D UV-C من Massphoton يمكن أن يقلل بشكل فعال من عدد البكتيريا الطبيعية في الهواء مع امتصاص الجسيمات في البيئة ، وحماية جزيئات الرائحة المعطاة.
الكلمات الرئيسية: LED UV-C ، البكتيريا الطبيعية ، المحفز الضوئي ، خالي من الأوزون ، مكافحة العدوى والوقاية منها
1. مقدمة
يؤثر تلوث الهواء بشدة على جوانب مختلفة من حياتنا ، بما في ذلك بيئات المعيشة والتعلم والعمل. تؤثر الملوثات مثل المركبات العضوية المتطايرة ، والمواد الجسيمية ، ومسببات الأمراض على صحة الجهاز التنفسي والعصبي ، في حين تؤثر الروائح الناتجة عن تخمير نفايات الطعام ، ورائحة المرحاض ، وتدخين السجائر سلبًا على الحالة المزاجية. بحث من قبل Sierra-Varga et al. وجدت أن الجسيمات التي يبلغ قطرها أقل من 2.5 ميكرومتر (PM2.5) في المنطقة السنخية من الرئتين [1]. من ناحية أخرى ، يتم تعليق مسببات الأمراض في الهواء في شكلين: القطرات (القطر> 5 ميكرومتر) والهباء الجوي (القطر ≤5 ميكرون) ، والتي يمكن أن تنشر الأمراض عبر الجهاز التنفسي. يمكن أن تعيش جزيئات الهباء الجوي ، على وجه الخصوص ، في المساحات المغلقة لساعات إلى أيام ودخول جسم الإنسان من خلال الجهاز التنفسي ، مما يسبب الالتهابات [2]. لقد تم إظهار خاصية النقل هذه بالكامل خلال الأوبئة الأخيرة ، مما يجعل معقمات الهواء حلاً تكنولوجيًا رئيسيًا لكسر سلسلة الإرسال. أظهرت معقمات الهواء إمكانات كبيرة في منع الأمراض المحمولة جواً وتقليلها [3]. تستخدم معقمات الهواء المشتركة في السوق تقنية الأشعة فوق البنفسجية (UV) في المقام الأول لتعقيمها. استخدام ضوء الأشعة فوق البنفسجية للمعقم له تاريخ لعدة عقود [4]. إن ضوء UVC ، بطول موجة يتراوح بين 100-280 نانومتر ، يعطل طيفًا واسعًا من الكائنات الحية الدقيقة ، بما في ذلك الفيروسات والبكتيريا والبروتوزوا والفطريات والخميرة والطحالب ، عن طريق تشكيل بيريميدين ثنائيات-قناة من المواد الوراثية-مثبتة الحماية من الحمض النووي الريبي [5 ، 6]. ومع ذلك ، فإن تقنية التشعيع التقليدية للأشعة فوق البنفسجية تستخدم طولًا موجيًا يبلغ 254 نانومتر ، والذي يحتوي على عيوب مثل استخدام الزئبق السام وحجم الجهاز الكبير وإنتاج الأوزون [7]. على النقيض من ذلك ، فإن LEDs UV-C التي تنبعث منها 275 نانومتر أصغر في الحجم ، وتوفر ناتجًا بصريًا أعلى ، ويزيل خطر تلوث الزئبق [8] ، وله عمر أطول ، ما يصل إلى 25000 ساعة ، وهو ما يتراوح من 2 إلى 25 مرة من 254 نانومتر من مصابيح بخار الزئبق [9 ، 10]. تركز هذه الدراسة على فعالية معقم التعقيم باستخدام تقنية UV-C LED لتنقية الهواء الداخلي ، مع مراقبة إزالة الروائح المحددة التي تؤثر على صحة الإنسان والرفاه والراحة. يوضح البحث تمامًا الإمكانات الكبيرة لتكنولوجيا UV-C LED في التحكم في الالتهابات المحمولة جواً ومنعًا لها ، مع معالجة الفجوة في تحسين نضارة الهواء لمثل هذه الأجهزة.
2. المواد والطرق
2.1 المواد
المعدات المستخدمة في هذه الدراسة هي معقمة الهواء Q6060-D UV-C من MassPhoton ، والتي تم تطويرها بشكل مستقل وإنتاجها بواسطة Massphoton. يدخل الهواء الطبيعي الجهاز عبر الفتحة الصغيرة في وسط الغطاء الأمامي تحت قوة المروحة. عندما يمر الهواء عبر مرشح HEPA ، يتم امتصاص الجزيئات الموجودة في الهواء ، والتي تشكل الخطوة الأولى من التطهير. ثم يدخل الهواء المصفى إلى وحدة LED UV-C ، حيث يتعرض للضوء فوق البنفسجي للمعقمة ، مما يمثل الخطوة الثانية من التعقيم. ثم يصل الهواء المعقم إلى وحدة المحفز الضوئي ، حيث يتم تنشيط المحفز الضوئي عن طريق الضوء المرئي ، مما يولد تفاعلًا تحفيزًا ضوئيًا يزيل جزيئات الرائحة من الهواء ، وهي الخطوة الثالثة من التخلص من الرائحة. بعد الخضوع لهذه العمليات الثلاث - التهيئة ، والتعقيم ، والتخلص من الرائحة - يتم إطلاق الهواء النقي في الغرفة عبر المسام حول الغلاف الأمامي للجهاز على طول القناة الهوائية. يوضح الشكل 1 العرض المنفجر للمنتج.

الشكل 1 وحدة تعقيم الهواء Q6060 -D UV -C من MassPhoton المستخدمة في هذه الدراسة: 1 -غطاء ، 2 -لوحة الإضاءة -قناة هواء عاكسة عالية الأشعة فوق البنفسجية ، 3 -مروحة Hepa ، 4 -UV -C LED ، 5 -وحدة التكاثر ، 6 -محفز ضوئي ، 7 -غطاء خلفي ، 8 -fan module , 9 -قناة التهوية.
2.2 الطرق
تشير طريقة أخذ العينات وصيغة الحساب إلى الملحق D من GB28235 - 'المتطلبات الصحية لجهاز Ultraviolet of Ofinfection ' لأخذ العينات. يتم إصدار هذه الطريقة من قبل إدارة الدولة لتنظيم السوق وإدارة توحيد جمهورية الصين الشعبية ، والتي تشغل منصب المعيار الوطني لجمهورية الصين الشعبية ، وأكثر احترافًا وعلميًا.
3. النتائج والمناقشات
3.1 معدل التعقيم
تم تثبيت من MassPhoton معقم الهواء Q6060-D UV-C على سقف غرفة اجتماعات الطابق السفلي 1 في مركز تجاري للتسوق في هونغ كونغ لاختبار معدل التخلص من البكتيريا الطبيعية. يتم استخدام غرفة الاجتماعات من الاثنين إلى الجمعة ، من الساعة 8:30 صباحًا إلى 11:30 صباحًا ، من قبل موظفي مكتب مول. لإنشاء مجموعة مراقبة ، تم قياس عدد مستعمرة البكتيريا المحمولة جواً بعد ثلاثة أيام من عدم التشغيل. تم جمع بيانات المجموعة التجريبية بعد ثلاثة أيام متتالية من التشغيل. تم إجراء أخذ العينات قبل وبعد الاجتماعات لمقارنة فعالية معقم الجهاز أثناء استخدام الغرفة المستمر. أظهرت النتائج متوسط معدل الإزالة بنسبة 59.5 ٪ قبل اجتماع الصباح (8:30 صباحًا) و 63.7 ٪ بعد الاستخدام المستمر طوال الصباح (11:30 صباحًا). يشير هذا إلى متوسط معدل القضاء بنسبة 61.6 ٪ خلال ساعات الاجتماع مع الجهاز في التشغيل المستمر (كما هو موضح في الجدول 1).
الجدول 1 Massphoton Q6060-D UV-C Air Sterilizer في قاعة المؤتمرات.
| Time | 8:30 صباحا | 11:30 صباحا |
| معدل التعقيم | 59.5 ٪ | 63.7 ٪ |
| متوسط معدل التعقيد | 61.6 ٪ | |
كما هو مبين في الشكل 2 ، فإن تصوير وسط الثقافة ، يظهر بوضوح انخفاضًا كبيرًا في البكتيريا الطبيعية المحمولة جواً بعد تشغيل معقم الهواء Q6060-D UV-C من Massphoton. هذا يدل على فعالية الجهاز في تقليل خطر انتقال المرض في البيئات المزدحمة.
الشكل 2 مثال على نتائج Petri-dish المقارنة عندما يكون معقم الهواء خارج وبعد أن يكون Air Sterilizerr Q6060-D UV-C من Massphoton قيد التشغيل.
تم إجراء تقييم على فعالية التطهير في Massphoton 06060-D UV-C Air معصور Air Air Air ضد البكتيريا المحمولة جواً في غرفة رفض تقع في الطابق الثاني من مركز تجاري في هونغ كونغ. بالنظر إلى نمط الإشغال غير المستقل للمساحة ، تم جمع عدد المستعمرة البكتيرية المحمولة جواً قبل أن يتم تشغيل Q6060-D UV-C Air Sterilizerr من R massphoton. بعد 3 ساعات من التشغيل ، تم قياس عدد المستعمرة البكتيرية المحمولة جواً مرة أخرى كمجموعة تجريبية. تم أخذ عينات من مستويات البكتيريا المحمولة جوا قبل وبعد تشغيل الجهاز لمدة 5 أيام متتالية ، مع النتائج التي تشير إلى متوسط معدل تخفيض البكتيريا 70.8 ٪ (الجدول 2).
الجدول 2 معدل المعقم غرفة القمامة.
| Time | اليوم 1 | اليوم 2 | اليوم 3 | اليوم 4 | اليوم 5 | متوسط معدل التعقيم |
| معدل التعقيم | 81.8 ٪ | 71.2 ٪ | 71.8 ٪ | 60.0 ٪ | 69.2 ٪ | 70.8 ٪ |
كما هو مبين في الشكل 3 ، يوضح أن المستعمرات البكتيرية في طبق الثقافة ، يشير أيضًا إلى انخفاض كبير في عدد البكتيريا الطبيعية بعد تشغيل الجهاز ، مما يسيطر بشكل فعال على نمو البكتيريا الطبيعية في غرفة القمامة ويقلل من خطر الإصابة بالمرض للموظفين عند التخلص من القمامة.

الشكل 3. مثال على نتائج Petri-dish المقارنة عندما يكون معقم الهواء خارج وبعد تعقيم الهواء Q6060-D UV-C من Massphoton.
3.2 تجربة إزالة الرائحة
اختر ممرًا وسقفًا فوق غرفة القمامة في الطابق الثالث من مركز للتسوق في هونغ كونغ لتثبيت 8 معقمات جوية Massphoton لاختبار فعالية إزالة الرائحة. يتم توصيل الممر بسيناريوهات متعددة ، بما في ذلك البار ، والباب الخلفي للمطبخ ، والراحة ، ومتجر الأمومة. بعد تشغيل الأجهزة ، تم إجراء قياسات مستمرة لمدة ثلاثة أيام لمراقبة وتحليل التغييرات في بيانات الاختبار. تم تشغيل معقمات الهواء في الساعة 8:00 صباحًا ، والتي تم تسجيلها على أنها 0H ، وتم تجميع الوقت بعد ذلك.
كما هو مبين في الشكل 3A ، بدأ متجر مستأجر التجديد بعد 7 ساعات من تنشيط المعقم الجوي. قبل التجديد ، كانت مستويات TVOC المقاسة طبيعية وأظهرت اتجاهًا تناقصًا. ومع ذلك ، بعد بدء التجديد ، ارتفعت مستويات TVOC من 0.01 ملغ/متر مكعب إلى 10.0 ملغ/متر مكعب ، وتم اكتشاف رائحة طلاء قوية في الهواء. بعد 10 ساعات من التشغيل ، تم قياس تركيز TVOC مرة أخرى ووجد أنه انخفض إلى 3.53 ملغ/متر مكعب ، مع انخفاض رائحة الطلاء بشكل كبير.
تم اختيار ثلاث نقاط لاختبار تركيز PM2.5: مدخل البار ومتجر الأمومة ، وعباحة الرجال والباب الخلفي للمطبخ ، والممر. وقد وجد أنه قبل ساعات العمل ، يمكن الحفاظ على تركيز PM2.5 أقل من 15 ميكروغرام/متر مكعب. ومع ذلك ، مع زيادة عدد الأشخاص ، أظهر تركيز PM2.5 اتجاهًا تصاعديًا طفيفًا ، لكن تشغيل المعقم الهوائي ساعد في الحفاظ على مستويات PM2.5 وتقليله في البداية. بالإضافة إلى ذلك ، لوحظ أن استخدام الطلاء أثناء التجديد لم يكن له أي تأثير على مستويات PM2.5 (كما هو مبين في الشكل 3 ب).

الشكل 4. إزالة TVOC و PM2.5 بواسطة آلة تعقيم الهواء Massphoton.
من نتائج الاختبار ، يمكن ملاحظة أن تركيز TVOC الكلي وتركيز المادة الجسيمية PM2.5 في البيئة موجود ضمن الإرشادات التي وضعتها HK EPD ومعايير الآبار. ومع ذلك ، يمكن أن يؤدي استخدام آلة تعقيم الهواء Massphoton إلى إزالة الغازات الضارة والجسيمات بشكل فعال من الهواء ، والحفاظ على جودة الهواء الداخلي وتوفير بيئة عمل وتسوق أكثر ملاءمة للعاملين في المكاتب والمتسوقين.
3.3 اختبار للأمونيا في السجائر
في غرفة مغلقة بحجم 112 متر مكعب داخل مقر المصنع ، تم تثبيت آلة تعقيد الهواء الشامل على السقف لاختبار فعاليتها في إزالة PM2.5 ، والفورمالديهايد ، و TVOC بعد حرق 4 سجائر ، وكذلك قدرتها على إزالة الأمونيا بعد تبخير 20 ملًا من محلول AMMANIA 10 ٪ لمدة 30 دقيقة.
تم إضاءة أربعة سجائر في وقت واحد داخل الغرفة. بعد حرقها تمامًا ، تم قياس التركيزات الأولية لـ PM2.5 ، والفورمالديهايد ، و TVOC باستخدام كاشف تركيز الفورمالديهايد المحمولة ، مع قيم 3.6 ميكروغرام/متر مكعب ، 0.12 جزء في المليون ، و 0.15 ملغ/م ، على التوالي. ثم تم تشغيل آلة تعقيد الهواء وتشغيلها بشكل مستمر لمدة 4 ساعات. بعد هذه الفترة ، تم قياس التركيزات مرة أخرى ، مما يدل على أن PM2.5 قد انخفض إلى 14 ميكروغرام/متر مكعب ، الفورمالديهايد إلى 0.01 جزء في المليون ، و TVOC إلى 0.01 ملغ/متر مكعب. كانت معدلات الإزالة 61.10 ٪ لـ PM2.5 ، 87.50 ٪ للفورمالديهايد ، و 98.20 ٪ لـ TVOC ، مما يقلل بشكل فعال من مستويات الغازات الضارة والجسيمات في المساحة المرفقة (كما هو مبين في الجدول 3).
الجدول 3 إزالة رائحة السجائر بواسطة آلة تعقيم الهواء Q6060-D UV-C من Massphoton.
| الوقت (ح) | قيمة القياس | معدل الإزالة | |
PM2.5 (UG/M 3) | 0H | 36 | 61.10 ٪ |
| 4H | 14 | ||
HCHO (جزء في المليون) | 0H | 0.12 | 87.50 ٪ |
| 4H | 0.01 | ||
TVOC (ملغ/م 3) | 0H | 0.15 | 98.20 ٪ |
| 4H | 0.01 |
باستخدام غاز الأمونيا لمحاكاة الرائحة في مرحاض ، تم وضع 20 مل من محلول الأمونيا بنسبة 10 ٪ في أطباق بتري φ90 × 18 مم. تم ترك الأطباق مكشوفة للسماح بالتبخر الطبيعي لمدة 30 دقيقة ، وتم قياس التركيز الأولي لـ NH₃ باستخدام كاشف غاز NH₃ المحمول كمجموعة التحكم. ثم تم تشغيل آلة تعقيم الهواء ، وتم اختبار تركيز الأمونيا الداخلي كل 10 دقائق. بعد تشغيل آلة تعقيم الهواء لمدة 90 دقيقة ، انخفض تركيز الأمونيا من 4.5 جزء في المليون إلى 0.2 جزء في المليون ، مما أدى إلى إزالة الأمونيا بنسبة 95.5 ٪ (كما هو مبين في الجدول 4).
الجدول 4 إزالة الأمونيا بواسطة من Massphoton معقمة الهواء Q6060-D UV-C
| الوقت (دقيقة) | قيمة القياس | معدل الإزالة | |
| NH3 (جزء في المليون) | 0 | 4.5 | 99.9 ٪ |
| 30 | 0.7 | ||
| 60 | 0.2 | ||
| 90 | 0.0 |
بالإضافة إلى البيانات التي يمكن ملاحظتها بصريًا المذكورة أعلاه ، قمنا أيضًا باختبار من MassPhoton معقم الهواء Q6060-D UV-C لقدرته على إزالة الروائح القوية مثل الروائح المليئة بالروائح الغذائية المتبقية. تم القضاء على هذه الروائح المكثفة تمامًا خلال ساعتين في غرفة مغلقة تبلغ 112 مترًا مكعبًا. توضح نتائج الاختبار الداخلي تمامًا أن جهاز تنقية الهواء Massphoton يمكنه إزالة روائح المعيشة الداخلية بشكل فعال ، مما يجعله مناسبًا للاستخدام في المطاعم والمنازل والمراحيض العامة وبيئات مماثلة أخرى.
4. الاستنتاجات
يستخدم من MassPhoton معقم الهواء Q6060-D UV-C تقنية أشباه الموصلات الصلبة [11] لإصدار ضوء LED UV-C بطول موجة واحد من 260-280 نانومتر. أظهرت التجارب الأولية أن نطاق الطول الموجي هذا لا ينتج الأوزون ، كما أنه لا يؤدي إلى تسرب ضوء الأشعة فوق البنفسجية [12]. هذه التكنولوجيا أكثر ملاءمة للبيئة ، ولديها عمر أطول ، وتستهلك طاقة أقل [7 ، 13]. بناءً على أساس الحفاظ على معدل تعقيم مرتفع للبكتيريا الطبيعية ، يضيف الإصدار 2.0 وحدة تحفيز ضوئي ومرشح للهواء الجسيمات عالي الكفاءة (HEPA). عند التعرض للضوء المرئي أو الضوء فوق البنفسجي [13] ، تنشط وحدة التحفيز الضوئي تفاعلًا تحفيزيًا ضوئيًا على سطح TiO2 ، مما يولد أنواع الأكسجين التفاعلية (ROS) مثل جذور الهيدروكسيل (OH-) وجذور الفائق أكسيد (O2-) [13]. هذه ROS لديها قدرات مؤكسدة قوية ويمكن أن تتحلل المركبات العضوية ، وبالتالي إزالة وتكسير المواد الرائحة [12] بفعالية. يتكون مرشح HEPA من ألياف متشابكة للغاية مع فجوات صغيرة جدًا بينهما ، مما يتيح له التقاط ملوثات جسيمات صغيرة في الهواء بشكل فعال. هذا يساعد على إزالة الجسيمات الدقيقة ، وتحسين جودة الهواء الداخلي [14] ، ومنع انتشار الأمراض.
يتميز من Massphoton من Massphoton معقم الهواء Q6060-D UV-C ، خالية من الزئبق ، خالية من الأوزون ، وتسرب الأشعة فوق البنفسجية ، إلى جانب التصميم المدمج والذكي. يسمح بالتعايش بين الإنسان والآلة ، ويزيل الروائح بكفاءة ، ويتضمن وحدة إنترنت الأشياء التي تتيح المراقبة في الوقت الفعلي لجودة الهواء الداخلي عبر تطبيق الهاتف المحمول. إنه مساعد ممتاز لتحسين جودة الحياة في بيئات مثل المنازل ومراكز التسوق والمكاتب. في المستقبل ، يمكن استكشاف مزيد من التحقق من صحة معقم AV-C UV-C من Q6060-D UV-C من MassPhoton في البيئات المتخصصة مثل المستشفيات.
مراجع
[1] Sierra-Vargas ، MP و LM Teran ، تلوث الهواء: التأثير والوقاية. علم التنفس: المجلة الرسمية للجمعية الآسيوية لعلم التنفس ، 2012. 17 (7): ص. 1031-1038.
[2] Rabaan AA ، Asam ، انتقال محمول جواً من انتقال SARS-Cov-2Airborne من SARS-COV-2 هو الطريق المهيمن للانتقال: القطرات والهباء. Infez Med ، 2021. 29 (1): 10-19.
[3] LU Song ، JZCW ، الكائنات الحية الدقيقة المسببة للأمراض جواً وتطوير تكنولوجيا تنظيف الهواء: مراجعة. 2022 ، مجلة المواد الخطرة ،: مجلة المواد الخطرة.
[4] نانوغرام ، ر. ، تاريخ تشعيع الجراثيم فوق البنفسجي لمعقار الهواء. تقارير الصحة العامة ، 2010. 125 (1): ص. 15-27.
[5] Bintsis T ، Lerr ، التطبيقات الحالية والمحتملة للضوء فوق البنفسجي في صناعة الأغذية - مراجعة نقدية. 2000.
[6] Yaun BR ، SSEJ ، Marcy JE. تثبيط مسببات الأمراض على المنتجات الطازجة عن طريق الطاقة فوق البنفسجية. 2004.
[7] Glaab J ، LNCH ، تعطيل البشرة المتسامح من مسببات الأمراض متعددة الأطراف باستخدام LEDs EUC-UVC. 2021.
[8] Singh D. ، SARV ، تقييم تعطيل SARS-COV-2 البديل على الأسطح وفي الهواء باستخدام تقنيات التدخل القائمة على الأشعة فوق البنفسجية والضوء الأزرق .. 2023.
[9] Gerchman ، Y. ، et al. ، تعقم UV-LED لفيروس كورونافروس: تأثير الطول الموجي. مجلة الكيمياء الضوئية وعلم الأمراض الضوئية ، ب. علم الأحياء: المجلة الرسمية للجمعية الأوروبية لعلم الأمراض الضوئية ، 2020. 212 {العدد} :: p. 112044-1- 112044-7.
[10] KOHS J ، LTGC ، دراسات على التأثيرات الفيروسية للأشعة فوق البنفسجية من 233 نانومتر و 275 نانومتر أطوال موجية .. 2024.
[11] Macisaac ، SA ، et al. التقارير العلمية ، 2023. 13 (1).
[12] شافا محمد ، FMAE ، دراسة تقنية UV-C LED على معقم الهواء داخل الباب: طريقة فعالة خالية من الزئبق وخالية من الأوزون لإشعاع الكائنات الحية الدقيقة المحمولة جواً. 2024 ، جمعية آلات الحوسبة ، نيويورك ، نيويورك ، الولايات المتحدة الأمريكية.
[13] فوستر ، هكتار ، وآخرون ، معقم التحفيز الضوئي باستخدام ثاني أكسيد التيتانيوم: الطيف وآلية النشاط المضاد للميكروبات. علم الأحياء الدقيقة التطبيقية والتكنولوجيا الحيوية ، 2011. 90 (6): ص. 1847-1868.
[14] تشن CF ، HCCY ، فعالية منظف الهواء HEPA على تحسين تركيز الجسيمات الداخلية 2.5. 2022.
ابق على اطلاع بأحدث المستجدات لدينا من أخبار، تقنيات، وفعاليات.